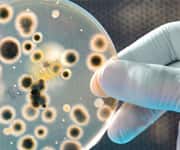
Weight Gain Linked to Poor Gut Bacteria

Life Extension Magazine®
Positive Lifestyle Changes Associated with Longer Telomeres | |
The results of a study described in The Lancet Oncology reveal that improvements in diet, exercise, stress management, and social support are associated with longer telomeres (DNA-protein complexes at the end of chromosomes which shorten with cellular aging).* The current study included 35 men with low-risk prostate cancer who had elected to undergo active surveillance. Ten men participated in the lifestyle intervention and 25 served as controls. Blood samples collected from the subjects at the beginning of the study and after five years were analyzed for peripheral-blood mononuclear cell telomere length and telomerase levels. Men who engaged in the lifestyle program had telomeres that were 10% longer on average at the end of the study, while the control group experienced an average 3% decrease in length. Greater adherence to lifestyle recommendations was associated with a corresponding increase in telomere length. Editor’s Note: The lifestyle program consisted of a diet high in whole foods, plant-based protein, fruit, vegetables, grains, and legumes that was low in fat and refined carbohydrates; a moderate aerobic exercise regimen, stress management consisting of yoga, meditation and relaxation, and weekly support group sessions. —D. Dye | |
| Reference | |
* Lancet Oncol. 2013 Sep 16. | |
Chronic Inflammation Impacts Healthy Aging | |
In the Canadian Medical Association Journal, Tasnime N. Akbaraly, PhD, of France’s Institut National de la Santé et de la Recherche Médicale and colleagues report that high levels of interleukin-6, which are elevated during chronic inflammation, are associated with a reduction in successful aging, which they define as the absence of chronic diseases and disability coupled with optimal physical, cognitive, cardiovascular, and respiratory functioning.* The study analyzed data from 3,044 middle-aged participants in the Whitehall II study, which examined 10,308 British civil servants every five years beginning in 1985. Subjects were categorized as having undergone successful aging, cardiovascular disease, noncardiovascular death, or normal aging over a 10-year follow up beginning in 1997-1999. Elevated levels of interleukin-6 reduced the odds of experiencing successful aging by 47%, elevated the risk of undergoing cardiovascular events by 64%, and more than doubled the risk of noncardiovascular death in comparison with subjects whose levels were lower. Editor’s Note: A high level of interleukin-6 was defined as more than 2.0 nanograms per liter at the two points at which it was measured. Supplements that help suppress IL-6 include: EPA, B6, DHEA, lycopene, luteolin, resveratrol, quercetin, and genistein among others. —D. Dye | |
| Reference | |
* CMAJ. 2013 Sep 16. | |
B Vitamin Supplementation Could Lower Stroke Risk | |
The results of a meta-analysis published in the journal Neurology indicate that supplementing with B vitamins could reduce the risk of experiencing a stroke.* Yuming Xu of Zengzhou University and colleagues selected 14 randomized, double-blinded trials that included a total of 54,913 subjects for their analysis. B vitamins administered in the trials included folate or folic acid, vitamin B6 and vitamin B12, and control groups were given a placebo or a very low-dose supplement. Follow-up times ranged from 24 to 80 months, during which 2,471 strokes occurred. All studies but one uncovered a decrease in supplemented subjects of serum homocysteine which, when elevated, is a risk factor for stroke. Reductions in serum homocysteine ranged from 3.1 to 10.4 mmol/L in vitamin-supplemented groups. When all trial participants were analyzed, overall stroke risk was reduced by 7% as a result of homocysteine reduction among supplemented participants in comparison with the control subjects. Editor’s Note: The authors conclude that, “B vitamin supplementation for homocysteine reduction significantly reduced stroke events, especially in subjects with certain characteristics who received appropriate intervention measure.” —D. Dye | |
| Reference | |
* Neurology. 2013 Sep 18. | |
Antioxidant Could Prevent Chemo Side Effect | |
An article published in the Annals of Neurology reveals that ethoxyquin, an antioxidant frequently used as a preservative in pet food, could help prevent peripheral neuropathy in patients treated with the chemotherapy drug paclitaxel (Taxol®).* Peripheral neuropathy is characterized by pain, numbness, and tingling in the extremities that can often persist years after the drug has been discontinued. By screening over two thousand compounds, Dr. Höke and his colleagues discovered that ethoxyquin and its derivatives protected against paclitaxel-induced peripheral neuropathy without affecting its ability to kill cancer cells. Giving ethoxyquin to mice treated with paclitaxel prevented two-thirds of the in-nerve degeneration that occurred in animals that did not receive the protective compound. The researchers hope to use the finding to develop a drug for humans undergoing paclitaxel treatment. Editor’s Note: The authors remark that, “Ethoxyquin and its novel derivatives as well as other classes of small molecules that act as heat shock protein 90 modulators may offer a new opportunity for development of drugs to prevent chemotherapy induced axonal degeneration.” —D. Dye | |
| Reference | |
* Ann Neurol. 2013 Sep 19. | |
Weight Gain Linked to Poor Gut Bacteria | |
An article published in the journal Nature reports the MetaHIT consortium’s finding of an association between gut bacterial “richness” and protection against obesity.* The current research compared the gut bacterial genes of 169 obese and 123 nonobese Danish men and women. It was discovered that approximately one-fourth of the participants had up to 40% fewer gut bacterial genes than the remainder of the study population and correspondingly fewer bacteria. This group also had less bacterial diversity. Subjects with low bacterial richness were significantly likely to have more adiposity or to be obese and to have gained more weight over the previous nine years. They were also more insulin resistant, more likely to be dyslipidemic, and had an increase in markers of inflammation and white blood cells, indicating a greater risk for diabetes or heart disease. Editor’s Note: The research team identified eight bacterial species as possibly preventive against weight gain. The findings could lead to new therapies for obesity or the development of diagnostic tests to identify those at risk of diseases linked to gut microbiome alterations. —D. Dye | |
| Reference | |
* Nature . 2013 Aug 29;500(7464):541-6. | |
Green Tea and Vitamin E Enhance Exercise Benefits in Older Men and Women | |
In an article published in the Journal of the American College of Nutrition, Israeli researchers report that drinking green tea and supplementing with vitamin E was associated with a reduction in waist circumference and fasting glucose among older adults who participated in a 12-week exercise program.* Twenty-two men and women received three cups of green tea and 400 IU vitamin E per day or a placebo over the course of an exercise program that involved 30 minutes of moderately intense walking six days per week. Although diet remained unchanged, all participants experienced a reduction in weight and fasting insulin levels. Average waist circumference declined from 39.7 inches to 38.15 inches among men who received green tea and vitamin E, and women’s waists declined from 37.7 inches to 33.5 inches by the end of the study. The green tea/vitamin E group additionally experienced a decrease in fasting glucose levels. Editor’s Note: Plasma protein carbonyls (a marker of oxidative stress) were also reduced, which was accompanied by a significant rise in red blood cell catalase activity at the end of the study period (indicating increased antioxidant protection) in the supplemented group. —D. Dye | |
| Reference | |
* J Am Coll Nutr. 2013 Feb;32(1):31-40. | |
Omega-3 Fatty Acid Could Help Protect the Brain From Effects of Alcohol | |
Results from a study presented at the 14th Congress of the European Society for Biomedical Research on Alcoholism, suggest a protective effect for docosahexaenoic acid (DHA), an omega-3 polyunsaturated fatty acid, against the development of dementia in alcoholics.* Dr. Collins and his associates administered DHA or no treatment to cultured adult rat brain cells prior to exposure to an amount of alcohol four times the legal limit established for driving. They observed a 90% reduction in neuroinflammation and neuronal death in DHA-treated cells in comparison to untreated cells. The team found that DHA suppressed PARP1, AQP4, and PLA2, which are factors potentiated by alcohol consumption, and that blocking PARP1 reduces binge alcohol-induced neurotoxicity. Dr. Collins emphasized that the amount of alcohol consumed by abusers still needs to be reduced in order to help protect brain function. Editor’s Note: In a previous analysis of 143 studies, Dr. Collins found an association between moderate social drinking and a lower risk of dementia and cognitive impairment. However, consuming larger amounts of alcohol results in inflammation, leading to increased oxidative stress and brain cell death, which is responsible for the greater risk of dementia experienced by alcoholics. —D. Dye | |
| Reference | |
* 14th Congress of the European Society for Biomedical Research on Alcoholism, 2013 Sep 8-11. Warsaw, Poland. | |
Americans Are Living Longer and Healthier | |
A study described in the American Journal of Public Health may help put to rest concerns that the longer life span looked forward to by the average American is bought at the price of an increased period of disability.* In a recent article, Allison Rosen, MD, and her colleagues report that not only can younger Americans expect to live longer than their counterparts of twenty years ago, but they can also anticipate that more of those years will be spent healthy. Dr. Rosen and her colleagues utilized data derived from the National Medical Expenditure Survey, National Health Interview Survey, Medical Expenditure Panel Survey, National Nursing Home Survey, and Medicare Current Beneficiary Survey. They determined that, in comparison with the quality-adjusted life expectancy (QALE) of two decades ago, the average 25-year-old living in the USA will experience 2.4 additional years of healthy life, and the average 65-year old will have 1.7 more years. Editor’s Note: “QALE tells us more than how long a person can expect to live,” Dr. Rosen explained. “It tells us what the relative quality of those added years are in terms of physical, emotional, and mental well-being. Though many studies have measured this in different ways, this is really the first time we’ve been able to capture this type of information across the whole US population over an extended period.” —D. Dye | |
| Reference | |
* Am J Public Health. 2013 Sep 12. | |
Alpha Lipoic Acid, Inositol Reduce Metabolic Syndrome in Postmenopausal Women | |
The journal Trials reported the outcome of a study which found a benefit for supplementing with alpha lipoic acid and inositol among postmenopausal women with metabolic syndrome.* The trial included women who had three or more of five metabolic syndrome components, and who were at increased risk of breast cancer as determined by family history or history of borderline lesions. Participants were instructed to consume a low-calorie diet and received alpha lipoic acid and inositol, or a placebo for six months. While the low-calorie diet slightly improved insulin resistance in the placebo group, a significant decrease in insulin occurred among 89.3% of women who received alpha lipoic acid and inositol, and a reduction in insulin resistance was observed in 66.7%. A greater percentage of women who received the supplements experienced reductions in triglycerides, waist circumference, and waist to hip ratio, as well as a significant increase in HDL. Editor’s Note: Metabolic syndrome is a cluster of symptoms that increase the risk of cardiovascular disease and diabetes. Postmenopausal women with metabolic syndrome are at greater risk of breast cancer than the rest of the female population. —D. Dye | |
| Reference | |
* Trials. 2013 Aug 28;14(1):273. | |
Trial Finds Benefit for Lycopene and Lutein in Adults with Subclinical Atherosclerosis | |
The results of a trial reported in the British Journal of Nutrition reveal an association between supplementation with the carotenoids lycopene and lutein and a reduction in carotid intima-media thickness (CAIMT), which is a measure of atherosclerotic plaque.* The study included 144 men and women with subclinical atherosclerosis, defined as CAIMT greater than 0.75 millimeters among those aged 59 years or younger and greater than 0.85 millimeters for subjects aged 60 and older. Participants were randomized to receive 20 milligrams lutein, 20 milligrams lutein plus 20 milligrams lycopene, or a placebo daily for one year. Doppler ultrasonography conducted at the beginning and end of the trial evaluated carotid artery intima-media thickness. While average carotid artery intima-media thickness did not change in the placebo group after a year, a significant reduction was observed in those who received lutein and among those who received lutein and lycopene. Editor’s Note: Participants who received both lutein and lycopene experienced the greatest reduction in CAIMT. —D. Dye | |
| Reference | |
* Br J Nutr. 2013 Sep 19. | |
Lower Diabetes Risk Found in Men with Higher Omega-3 Polyunsaturated Fatty Acid Levels | |
An article published in Diabetes Care reports an association between higher serum levels of omega-3 polyunsaturated fatty acids and a reduction in the risk of type II diabetes.* Researchers at the University of Eastern Finland evaluated data from 2,212 men who participated in the Kuopio Ischaemic Heart Disease Risk Factor Study. Blood samples were analyzed for the omega-3 fatty acids EPA, DPA, DHA, and ALA, and hair samples were analyzed for mercury, a common contaminant of fish that may modify the effect of omega-3 fatty acids on diabetes risk by increasing insulin resistance. Over a 19.3 year average follow-up, type II diabetes was diagnosed in 422 subjects. Men whose combined serum EPA, DPA, and DHA levels were among the top 25% of participants had a risk of diabetes that was one-third less than those whose levels were among the lowest fourth. Editor’s Note: When individual long-chain fatty acids were analyzed, DHA and DPA emerged as protective against type II diabetes. No effect of mercury on diabetes risk was found. —D. Dye | |
| Reference | |
* Diabetes Care. 2013 Sep 11. |